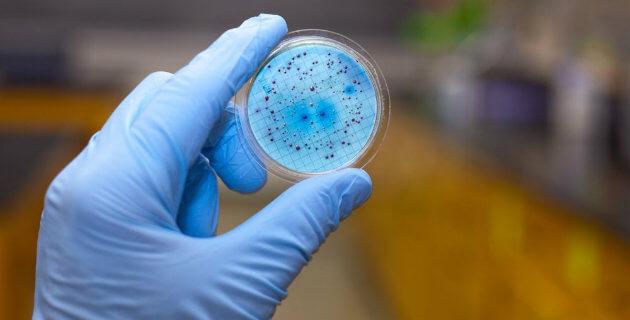

La hepatitis vírica es uno de los principales problemas sanitarios tanto en los países en desarrollo como en los desarrollados. Este trastorno está causado por al menos cinco virus hepatotropos reconocidos hasta la fecha: por estos tipos de hepatitis A, B, C, D y E.
Otros muchos virus pueden causar hepatitis, generalmente como parte de una enfermedad sistémica; incluyen los virus del herpes simple (VHS), citomegalovirus (CMV), virus de Epstein-Barr, virus de la varicela-zóster, VIH, virus de la rubéola, adenovirus, enterovirus, parvovirus B19 y arbovirus.
El virus de la hepatitis G (VGB) y el virus transmitido por transfusión (VTT) infectan con frecuencia el hígado como coinfección con otro virus hepatotropo y pueden producir viremia aguda o crónica, pero rara vez producen lesión hepatocelular por sí mismos.
Los virus hepatotropos constituyen un grupo heterogéneo de agentes infecciosos que causan enfermedad clínica aguda similar.
En la mayoría de los pacientes pediátricos, la fase aguda no causa enfermedad clínica o ésta es leve. La morbilidad se relaciona con los casos infrecuentes de insuficiencia hepática aguda desencadenada en los pacientes susceptibles y hasta el estado de enfermedad crónica y las complicaciones acompañantes que pueden causar tres de estos tipos de hepatitis (B, C, D).
Dado que la epidemiología de estas formas de hepatitis vírica varía ampliamente según la localización geográfica, así lo hace su repercusión médica.
Aspectos comunes de los tipos de hepatitis
En el período de recién nacido, la infección es una causa común de hiperbilirrubinemia de reacción directa; la causa infecciosa es un agente bacteriano (Escherichia coli, Listeria) o uno de los virus no hepatotropos (VHS, enterovirus, CMV). Siempre se deben excluir las causas metabólicas y anatómicas (tirosinemia, atresia biliar, quistes colédocos).
En la infancia se deben excluir la obstrucción hepática (cálculos biliares, colangitis esclerosante primaria, patología pancreática), afecciones inflamatorias (hepatitis autoinmunitaria, artritis reumatoide juvenil, enfermedad de Kawasaki, disregulación inmunitaria), trastornos infiltrativos (tumores malignos), toxinas/medicaciones, trastornos metabólicos (enfermedad de Wilson, fibrosis quística) o una infección (VEB, varicela, paludismo, leptospirosis o sífilis).
Tipos de hepatitis
Hepatitis A
Este virus es también responsable de la mayoría de las formas de hepatitis agudas y benignas; aunque puede ocurrir insuficiencia hepática fulminante, es infrecuente y ocurre con mayor frecuencia en adultos que en niños.
Como es el mecanismo de transmisión El VHA es muy contagioso. La transmisión es casi siempre por contacto de persona a persona. Se propaga sobre todo por vía fecal-oral.
La transmisión parenteral de estos tipos de hepatitis se produce raramente; no se reconoce otra forma de transmisión. La infección por VHA durante el embarazo o en el momento del parto no parece aumentar las complicaciones de la gestación ni enfermedades del recién nacido.
Manifestaciones clínicas
El VHA es responsable de la hepatitis aguda solamente. Con frecuencia se trata de una enfermedad anictérica, con síntomas clínicos indistinguibles de otras formas de gastroenteritis vírica, sobre todo en los niños jóvenes.
La enfermedad tiene una probabilidad muy superior de ser sintomática en los adolescentes mayores o adultos, en pacientes con trastornos hepáticos de base y en los inmunocomprometidos.
Se trata característicamente de una enfermedad aguda febril con un comienzo súbito de anorexia, náuseas, malestar, vómitos e ictericia.
La duración típica de la enfermedad es de 7 a 14 días. Otros órganos y sistemas pueden verse afectados durante la infección aguda por el VHA. Los ganglios linfáticos regionales y el bazo pueden hallarse aumentados de tamaño. La médula ósea puede hallarse moderadamente hipoplásica y se ha descrito anemia aplásica.
El tejido del intestino delgado puede mostrar cambios en la estructura de las vellosidades y puede producirse ulceración del tracto gastrointestinal, especialmente en los casos fatales.
Se han descrito pancreatitis y miocarditis agudas, aunque raramente, y pueden producirse nefritis, artritis, vasculitis y crioglobulinemia como consecuencia de inmunocomplejos circulantes.
Como se diagnostica
La infección aguda por el VHA se diagnostica detectando anticuerpos al VHA, específicamente anti-VHA (inmunoglobulina [Ig] M) por radioinmunoensayo o, rara vez, por identificación de partículas víricas en las heces.
Complicaciones
En estos tipos de hepatitis dejan secuelas como:
Insuficiencia hepática aguda (IHA) por infección por el VHA, una complicación rara pero no infrecuente del VHA. Los que se encuentran en riesgo de esta complicación son adultos, pero también los pacientes con trastornos hepáticos de base o los inmunocomprometidos.
La altura de la viremia por el VHA puede relacionarse con la gravedad de la hepatitis. El VHA puede progresar a un síndrome de colestasis prolongada que aparece y desaparece durante muchos meses. El prurito y la malabsorción grasa son problemáticos y requieren soporte sintomático con medicaciones antipruriginosas y vitaminas liposolubles.
Este síndrome se da en ausencia de cualquier disfunción de la síntesis hepática y se resuelve sin dejar secuelas.
Tratamiento
No hay tratamiento específico para estos tipos de hepatitis A. El tratamiento de soporte consta de hidratación intravenosa según necesidades y agentes antipruriginosos y vitaminas liposolubles para la forma colestásica prolongada de la enfermedad.
Puede salvar la vida del paciente la monitorización seriada en busca de signos de insuficiencia hepática aguda y una remisión temprana a un centro de trasplantes.
Prevención
Los pacientes infectados por el VHA son contagiosos desde 2 semanas antes y hasta aproximadamente 7 días después del comienzo de la ictericia y deben ser excluidos de la escuela, guarderías o trabajo durante este período.
Es necesario lavarse cuidadosamente las manos, sobre todo después de cambiar la ropa interior y antes de preparar o servir la comida. En el medio hospitalario se recomiendan las precauciones de contacto y habituales 1 semana después del comienzo de los síntomas.
Vacuna
La disponibilidad de dos vacunas frente al VHA inactivadas, muy inmunogénicas y seguras, ha tenido un enorme impacto sobre la prevención de la infección por VHA. Ambas se han aprobado para niños >1 año de edad. Se administran por vía intramuscular en dos dosis, la segunda 6-12 meses después de la primera. La tasa de seroconversión infantil supera el 90% tras la dosis inicial y se acerca al 100% tras la segunda dosis.
Se ha utilizado la inmunización en masa de niños en edad escolar cuando las epidemias se han centrado en centros escolares. La vacuna es eficaz para lograr frenar los brotes de hepatitis A y también cuando se administran después de la exposición, debido a la rápida seroconversión y al largo período de incubación de la enfermedad. Sin embargo, los datos disponibles son aún insuficientes para recomendar la vacuna del VHA sola para la profilaxis postexposición.
Pronostico
El pronóstico es excelente, sin secuelas a largo plazo. La única temible complicación es la IHA. Sin embargo, la infección por el VHA sigue siendo causa de morbilidad grave y tiene un elevado impacto socioeconómico en las epidemias y en áreas endémicas.
Hepatitis B
El VHB tiene una diseminación por todo el mundo, y se calcula que 400 millones de personas se infectan crónicamente. Las El VHB se halla presente en elevadas concentraciones en la sangre, suero y exudados serosos y en concentraciones moderadas en saliva, a la sangre y el contacto sexual.
Los factores de riesgo para la infección por el VHB para estos tipos de virus niños y adolescentes incluyen la adquisición intravenosa por drogas o productos de la sangre, acupuntura o tatuajes, contacto sexual, cuidados institucionales y contacto íntimo con portadores.
En el 40% de los casos no se identifican factores de riesgo. No se cree que el VHB se transmita por exposición indirecta, como compartir los juguetes. El factor de riesgo más importante para adquirir el VHB en niños sigue siendo la exposición perinatal cuando la madre es HBsAg positiva
El riesgo máximo de transmisión se da cuando la madre también es portadora del antígeno HBeAg; hasta el 90% de los hijos de tales madres padecen infección crónica si no se les trata; se produce infección intrauterina en el 2,5% de sus niños.
En la mayoría de los casos, los marcadores serológicos de infección y la antigenemia aparecen 1-3 meses después del nacimiento, lo que sugiere que la transmisión ha ocurrido en el momento del parto; la fuente puede ser el virus presente en el líquido amniótico, en las heces o en la sangre de la madre. La inmunoprofilaxis de los lactantes es una medida muy eficaz de prevenir la infección y protege a >95% de los niños
El riesgo de infección crónica es del 90% en niños <1 año de edad; el riesgo es del 30% en los niños de 1 a 5 años y del 2% en los adultos. La infección crónica se asocia con el desarrollo de hepatopatía crónica, así como con el carcinoma hepatocelular.
El riesgo de carcinoma es independiente de la presencia de cirrosis y fue la muerte relacionada con cáncer más prevalente en adultos jóvenes en Asia, en donde la HVB era endémica
Manifestaciones clínicas
La primera prueba bioquímica que se realiza a estos tipos de hepatitis es la elevación de los niveles de ALT, que empiezan a aumentar justo antes de la aparición de letargo, anorexia y malestar, que tienen lugar alrededor de 6-7 semanas después de la exposición.
En algunos niños la enfermedad puede venir precedida de pródromos similares a la enfermedad del suero caracterizados por artralgia o lesiones cutáneas, como urticaria o erupción purpúrica, macular o maculopapular. También puede producirse acrodermatitis papular, el denominado síndrome de Gianotti-Crosti.
Otras enfermedades extrahepáticas asociadas con infecciones por VHB en niños son poliarteritis, glomerulonefritis y anemia aplásica. La ictericia, que puede existir en el 25% de los individuos, suele comenzar la 8.ª semana después de la exposición y dura l4 semanas. En la evolución normal de la resolución de la infección por VHB, los síntomas duran 6-8 semanas.
El porcentaje de niños con signos clínicos de hepatitis es más elevado con VHB que con VHA, y la tasa de IHA también es mayor. La mayoría de los pacientes se recuperan, pero el «estado de portador crónico» complica hasta el 10% de los casos adquiridos en la adultez.
La tasa de adquisición de la infección crónica depende en gran medida del modo y de la edad de adquisición, y es de hasta el 90% en los casos perinatales. La cirrosis y el carcinoma hepatocelular se observan con la infección crónica.
Complicaciones
La IHA con coagulopatía, encefalopatía y edema cerebral es más frecuente por VHB que por el resto de virus hepatotrópicos. El riesgo de IHA aumenta más cuando hay infección simultánea o sobreinfección por VHD. La mortalidad por esta complicación es >30%. El trasplante de hígado es el único tratamiento eficaz; la única opción alternativa son los cuidados paliativos de soporte, y una remisión temprana a un centro de trasplantes puede salvar la vida del paciente.
La infección por el VHB puede dar lugar también a hepatitis crónica, que puede llevar a cirrosis, complicaciones de la hepatopatía terminal y carcinoma hepatocelular primario. La glomerulonefritis membranosa con depósito de complemento y HBeAg en los capilares glomerulares es una complicación rara de estos tipos de hepatitis
Tratamiento
No hay en la actualidad ningún tratamiento médico fiablemente satisfactorio para la mayoría de personas infectadas por VHB.
Prevención Existe una vacuna frente a la hepatitis B e inmunoglobulinas B (IGHB) para prevenir estos tipos de hepatitis.
Deben quedar identificados y vacunados los contactos familiares, sexuales y compartidores de agujas si son susceptibles a la infección por el VHB.
Se debe aconsejar a los pacientes sobre el riesgo de contacto perinatal e íntimo de transmisión del VHB. El VHB no se disemina por la alimentación a pecho, besos, abrazarse o compartir agua o utensilios.
Los niños con VHB no deben ser excluidos de la escuela, juegos, guarderías o trabajo, a menos que sean propensos a morder. Un grupo de apoyo podría ayudar a los niños a hacer frente del mejor modo posible a su enfermedad. Todos los individuos HBsAg positivos deben ser notificados al departamento de salud estatal o local, y se diagnostica cronicidad si siguen siendo positivos después de 6 meses.
Pronostico
En general, el desenlace después de una infección aguda por el VHB es favorable, a pesar del riesgo de IHA. El riesgo de desarrollo de infección crónica hace que los riesgos de la cirrosis hepática y del carcinoma hepatocelular sean muy importantes.
La transmisión perinatal que lleva a cronicidad es responsable de la alta incidencia de carcinoma hepatocelular en adultos jóvenes en áreas endémicas. Es importante señalar que la infección por el VHB y sus complicaciones se controlan de modo efectivo por la vacunación para estos tipos de hepatitis.
Hepatitis C
El VHC es la causa de la mayoría de los casos previamente conocidos como hepatitis no A no B «relacionada con transfusión».
Como se trasmite
En este país, los factores de riesgo de transmisión de VHC incluían previamente la transfusión de sangre como la vía de infección más común, pero, con las actuales prácticas de cribado, el riesgo de transmisión de VHC es ahora del 0,001% por unidad transfundida. La transmisión sexual, en especial a través de varias parejas sexuales, es la segunda causa más habitual de infección de estos tipos de hepatitis mas peligrosos. Alrededor del 10% de las infecciones nuevas no tienen origen de transmisión conocida. En niños, la transmisión perinatal es el modo más prevalente de transmisión.
Se produce la transmisión vertical en hasta el 5% de los niños lactantes nacidos de madres virémicas. La coinfección por el VIH y unos títulos de viremia elevada (ARN del VHC positivo) en la madre pueden aumentar la tasa de transmisión hasta el 20%. El período de incubación es de 7-9 semanas (intervalo de 2-24 semanas).
Manifestaciones clínicas
La infección aguda por el VHC tiende a ser leve y de comienzo insidioso en estos tipos de hepatitis. Rara vez se produce insuficiencia hepática aguda.
Sin embargo, el VHC es el virus hepatotrópico con probabilidad mayor de causar infección crónica (En adultos infectados, <15% eliminan el virus; el resto desarrollan hepatitis crónica. En estudios pediátricos, el 6-19% de los niños lograron una eliminación sostenida espontánea del virus durante un seguimiento de 6 años, con independencia del modo de adquisición. La hepatitis C crónica es también clínicamente silente hasta que se desarrolla una complicación. Los niveles séricos de aminotransferasas fluctúan y en ocasiones son normales, pero la inflamación histológica es universal. La progresión de la fibrosis hepática es lenta durante varios años, a menos que haya factores comórbidos, que pueden acelerar la progresión de la fibrosis en estos tipos de hepatitis.
Aproximadamente el 25% de los pacientes infectados presentan cirrosis, insuficiencia hepática y, en ocasiones, carcinoma hepatocelular (CHC) en los 20-30 años desde el comienzo de la infección aguda. Aunque la progresión es rara en la edad pediátrica, se ha descrito cirrosis y CHC por el VHC en niños de edades a largo plazo constituyen la base teórica para el diagnóstico y el tratamiento en los niños con VHC.
La infección crónica por el VHC puede asociarse con vasculitis de los pequeños vasos y es una causa común de crioglobulinemia esencial mixta. Otras manifestaciones extrahepáticas observadas predominantemente en adultos incluyen vasculitis cutánea, neuropatía periférica, cerebritis, glomerulonefritis membranoproliferativa y síndrome nefrótico.
También puede haber anticuerpos frente al músculo liso, anticuerpos antinucleares y puede haber bajos niveles de anticuerpos antitiroideos
Complicaciones
El riesgo de insuficiencia hepática aguda debida al VHC es bajo, pero el riesgo de hepatitis crónica es el mayor de todos los virus hepatotropos. En adultos, los factores de riesgo de progresión a fibrosis hepática incluyen una edad más avanzada, obesidad, sexo varón e incluso una ingesta moderada de alcohol (dos bebidas de 30 ml al día).
La progresión a la cirrosis o CHC es una causa mayor de morbilidad y la indicación más frecuente para trasplante hepático en adultos de estos tipos de hepatitis.
Prevención
No se dispone de vacuna para prevenir el VHC. Las preparaciones de inmunoglobulina no son beneficiosas.
Pronostico
Se deben comprobar los títulos víricos anualmente para documentar una remisión espontánea. En la mayoría de los pacientes se desarrolla hepatitis crónica. El daño hepático progresivo es mayor en los pacientes con factores comórbidos tales como consumo de alcohol, variaciones en el genotipo vírico y predisposiciones genéticas de base para estos tipos de hepatitis.
Se aconseja con firmeza la remisión a un gastroenterólogo pediátrico para aprovecharse de los regímenes de monitorización actualizados y para optimizar su entrada en los protocolos de tratamiento cuando se disponga de ellos.
Hepatitis D
El VHD, el más pequeño de los virus conocidos, se considera defectuoso por su incapacidad para producir infección sin la concurrencia del virus VHB.
Como se trasmite
El VHD no produce infección si no es con la ayuda del VHB. Se pueden producir ambas al mismo tiempo (coinfección) o infectar a una persona que ya estaba infectada por VHB (sobreinfección). La transmisión suele producirse por contacto entre familiares o por contacto íntimo en zonas de gran prevalencia, que son sobre todo países subdesarrollados
La hepatopatía en la hepatitis VHD no tiene rasgos distintivos, a excepción de una gravedad mayor. En contraste con el VHB, el VHD lesiona directamente por un mecanismo citopático. Muchos de los casos más graves de infección por VHB parecen ser el resultado de la coinfección por VHB y VHD.
Signos y síntomas
Los síntomas de infección por estos tipos de hepatitis son similares, pero más graves, que los producidos por otros virus hepatotrópicos. El curso clínico depende del mecanismo de infección. En la coinfección es habitual la hepatitis aguda, mucho más grave que la infección exclusiva por VHB, pero el riesgo de evolución a hepatitis crónica es bajo.
En la sobreinfección la enfermedad aguda esinfrecuente, pero la hepatitis crónica es habitual. Sin embargo, el riesgo de IHA es mayor en la sobreinfección. Debe pensarse en hepatitis D en todo niño con insuficiencia hepática aguda.
Complicaciones
Debe considerarse la posibilidad de VHD en todos los casos de IHA. La coinfección con el VHB puede dar lugar también a una enfermedad crónica más grave ene estos tipos de hepatitis.
Tratamiento
El tratamiento se basa en medidas de soporte una vez se identifica la infección. Hasta la fecha no se dispone de tratamientos específicamente dirigidos al VHD. El tratamiento se basa fundamentalmente en controlar y tratar la infección por el VHB, sin el que el VHD no puede inducir hepatitis.
Prevención
No hay vacuna para la hepatitis D. Dado que la replicación de VHD no se produce sin la coinfección por virus de la hepatitis B, la inmunización contra VHB también previene la infección por VHD. La vacuna de la hepatitis B y las IGHB se usan con las mismas indicaciones que para la hepatitis B sola.
Hepatitis E
No se ha aislado el VHE, pero se ha clonado mediante técnicas moleculares. Este virus ARN tiene forma de esfera con espículas sin cubierta y su estructura es similar a la de los calicivirus.
Como se trasmite
La hepatitis E es la forma epidémica de lo que antes se denominaba hepatitis no A no B. La transmisión es fecal-oral (con frecuencia de transmisión hídrica) y se asocia con la eliminación del virus en las heces en forma de partículas de 27-34 nm. El VHE parece actuar como un virus citopático. Los hallazgos anatomopatológicos son similares a los de otros virus de la hepatitis.
Manifestaciones clínicas
La enfermedad que produce la infección por VHE es similar a la del VHA, pero suele ser más grave. Como con el VHA, no hay enfermedad crónica. Además de causar un cuadro más grave que el VHA, el VHE tiende a afectar a pacientes mayores, de 15-34 años. El VHE es un patógeno mayor en las mujeres embarazadas, en las que causa IHA con una elevada tasa de mortalidad para estos tipos de hepatitis.
Complicaciones
El VHE se asocia con un riesgo elevado de muerte en mujeres embarazadas. No se reconocen otras complicaciones en asociación con estos tipos de hepatitis.
Prevención
Una vacuna recombinante de la hepatitis E es muy eficaz en adultos. No hay datos que sugieran que la inmunoglobulina sea eficaz en la prevención de las infecciones por el VHE. La inmunoglobulina del fondo común de pacientes de áreas endémicas puede mostrarse eficaz para estos tipos de hepatitis.
La entrada 5 Tipos de Hepatitis Que No Sabias aparece primero en Mega Medico.